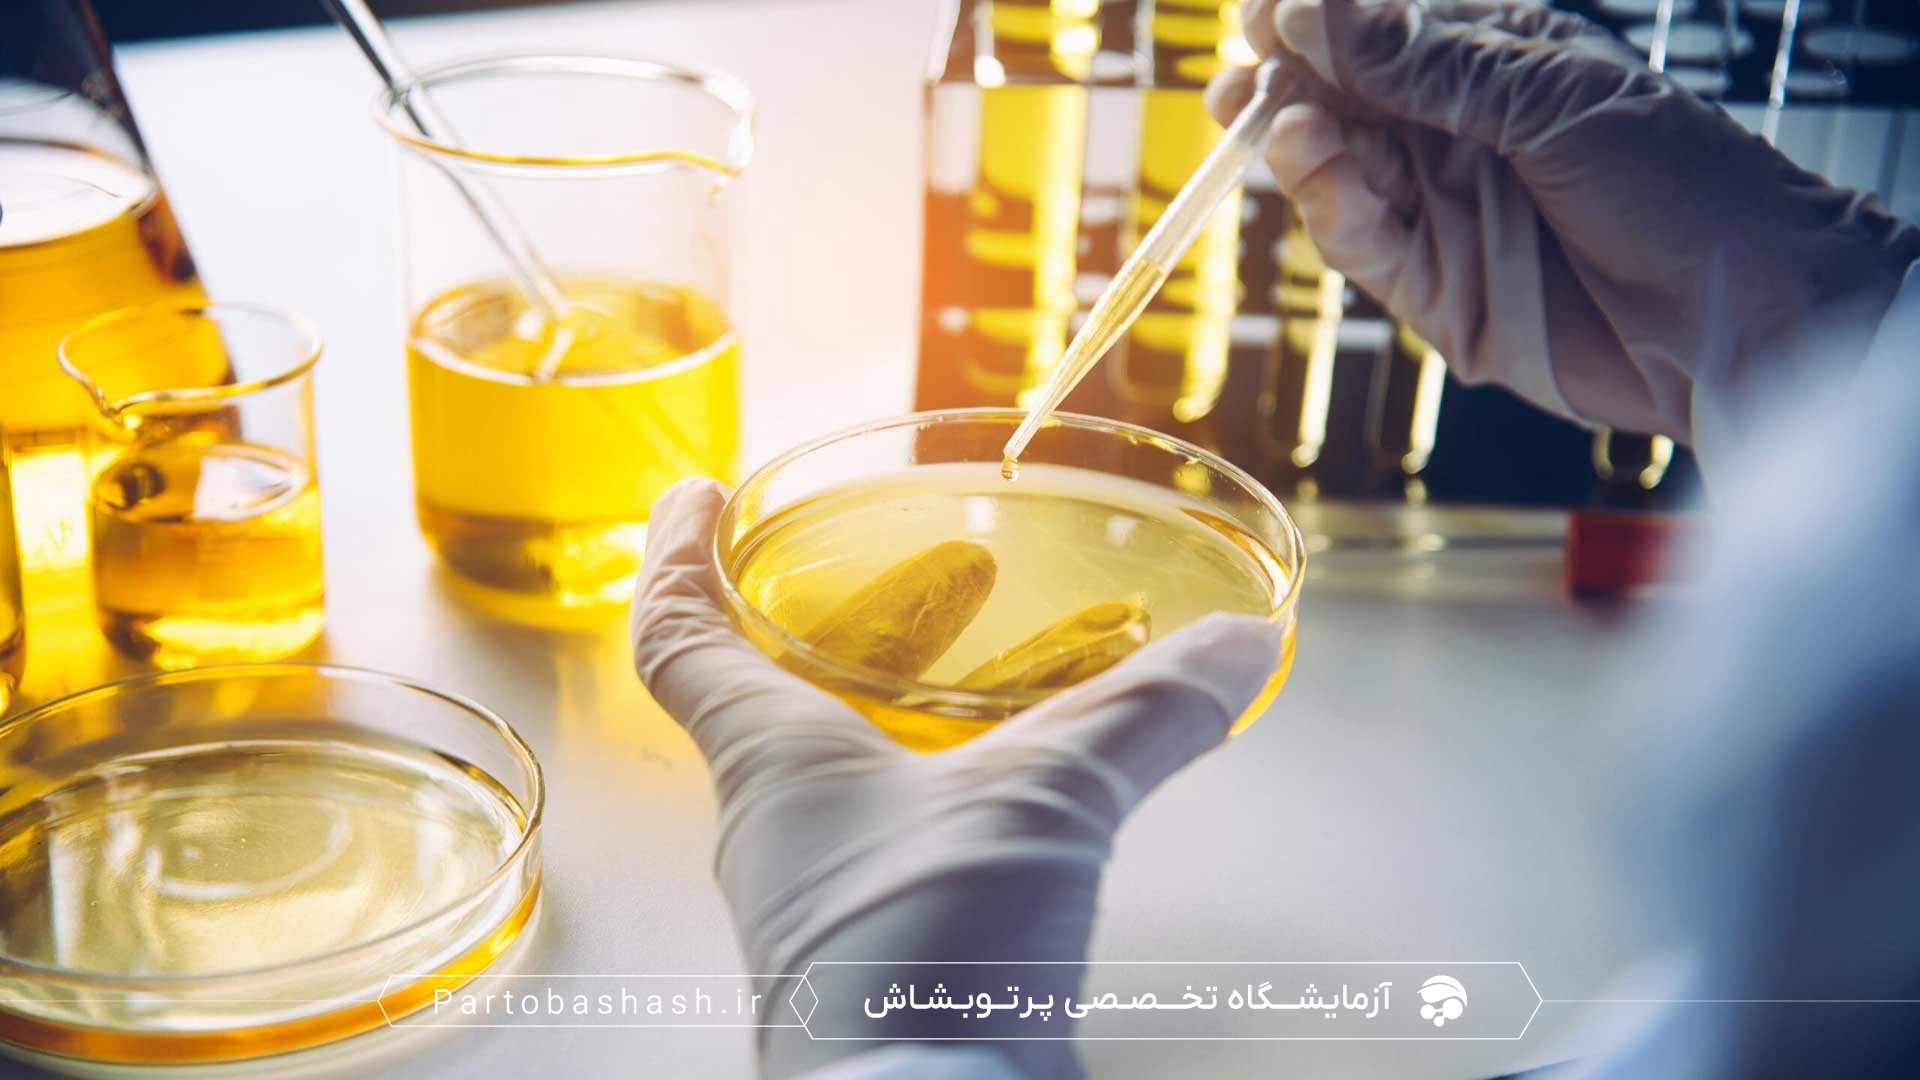
کنترل طعم و بوی اکسیداتیو در کره و روغنهای لبنی با آنالیز ویتامینها و فلزات توسط HPLC

کنترل طعم و بوی اکسیداتیو در کره و روغنهای لبنی: شاخصهای شیمیایی کلیدی
اکسیداسیون چربیها یکی از فرآیندهای شیمیایی مهم و رایج در کره و روغنهای لبنی است که میتواند تاثیر قابل توجهی بر کیفیت، طعم و بوی محصولات لبنی داشته باشد. این پدیده علاوه بر کاهش ارزش غذایی، میتواند به ایجاد ترکیبات نامطلوب و حتی مضری منجر شود که برای سلامت مصرفکنندگان نیز اهمیت دارد. در این مقاله به بررسی شاخصهای شیمیایی موثر در تشخیص و پایش اکسیداسیون و راهکارهای کنترل طعم و بوی اکسیداتیو در کره و روغنهای لبنی میپردازیم.
مقدمه
تعریف اکسیداسیون و تاثیر آن بر کیفیت چربیهای لبنی
اکسیداسیون چربی به واکنش چربیها با اکسیژن هوا گفته میشود که معمولاً شامل دو مرحله اصلی اکسیداسیون اولیه و ثانویه است. در مرحله اولیه، ترکیبات پراکسید (پرکسیدها) تشکیل میشوند و در مرحله ثانویه شکستن این ترکیبات به آلدهیدها، کتونها، اسیدها و سایر مواد فرار رخ میدهد. این فرآیند منجر به ایجاد طعم و بوی نامطبوع، کاهش کیفیت حسی و کاهش مواد مغذی مانند ویتامین E و دیگر آنتیاکسیدانها میشود.
در محصولات لبنی مانند کره و روغنهای لبنی، که چربی اصلی و فراوان دارند، اکسیداسیون میتواند سایر ویژگیهای فیزیکی مانند رنگ، قوام و پایداری محصول را نیز مختل کند. به همین دلیل، کنترل طعم و بوی اکسیداتیو در این محصولات از اهمیت بالایی برخوردار است و به کمک شاخصهای شیمیایی خاص قابل ارزیابی و پایش است.
شاخصهای شیمیایی کلیدی در تشخیص اکسیداسیون
پرکسید ارزش (Peroxide Value)
پرکسید ارزش یا Peroxide Value یکی از شاخصهای اولیه برای ارزیابی اکسیداسیون چربیها است و میزان ترکیبات پراکسید اولیه را اندازهگیری میکند. این شاخص در آزمایشهای کنترل کیفیت کره و روغنهای لبنی به کمک روشهای استاندارد مانند ASTM یا ISO قابل تعیین است.
در آزمایشگاههای تخصصی مانند آزمایشگاه کنترل کیفیت پرتو بشاش، روشهای تیتراسیون مکانیکی و یا دستگاهی به کار گرفته میشود و برای نتایج دقیقتر، استفاده از تکنیکهای پیشرفته مانند HPLC یا LC-MS نیز معمول است.
- ارزش بالای پرکسید بیانگر شروع فرآیند اکسیداسیون و کاهش کیفیت محصول است.
- پرکسید ارزش معمولاً باید زیر حد مطلوب استانداردهای ISIRI و Codex حفظ شود.
اسیدیته آزاد (Free Fatty Acids)
اسیدیته آزاد میزان اسیدهای چرب آزاد را در محصول نشان میدهد که میتواند ناشی از هیدرولیز و یا تخریب چربیها در اثر شرایط نامطلوب نگهداری باشد. افزایش FFA باعث بروز طعم تلخ و ناخوشایند در کره و روغنهای لبنی میشود.
اندازهگیری اسیدیته آزاد معمولاً توسط روشهای تیتراسیون با استفاده از محلول سود، و در برخی موارد از طریق تکنیکهای کروماتوگرافی مایع با کارایی بالا (HPLC) انجام میشود.
مقدار کتونها و آلدهیدها
اکسیداسیون ثانویه منجر به تولید ترکیبات فرار مانند کتونها و آلدهیدها میشود که عامل اصلی طعم و بوی نامطبوع اکسیداتیو هستند. این ترکیبات در غلظتهای پایین میتوانند حتی تغییراتی کوچک در طعم کره ایجاد کنند که برای مصرفکننده قابل ردیابی است.
اندازهگیری این ترکیبات عمدتاً با استفاده از تکنیکهای گازکروماتوگرافی همراه با طیفسنجی جرمی (GC-MS)، HPLC و یا دستگاههای سنجش اختصاصی انجام میشود که امکان تشخیص دقیق و سریع در آزمایشگاههای تخصصی کنترل کیفیت را فراهم میکند.
اندازهگیری ترکیبات پراکسید شده
در کنار پرکسید ارزش، بررسی دقیقتر ترکیبات پراکسید شده با روشهایی مانند پرپاکسایدهای هیدروپراکسید، ترکیبات پراکسی اسید و هیدروکسی اسید انجام میشود. این روشها با دستگاههای پیشرفته مانند LC-MS و ICP-OES میتوانند آلودگیهای فلزی و اثر آنها در تسریع اکسیداسیون را نیز مشخص کنند.
آزمایشهای دقیق و منظم با روشهای QA/QC طبق استانداردهای بینالمللی مانند Codex و ISO تضمین کننده کیفیت و پایداری کره و روغنهای لبنی در بازار خواهد بود.
روشهای کنترل و پایش اکسیداسیون در کره و روغنهای لبنی
استانداردهای کیفیت و الزامات آزمایشگاهی
برای پایش اکسیداسیون در محصولات لبنی، آزمایشگاههای تخصصی باید تحت سیستمهای کنترل کیفیت (QA/QC) پیشرفته و مطابق با استانداردهای ملی و بینالمللی ISIRI، ISO 22000 و Codex فعالیت کنند. نمونهبرداری اصولی، انجام آزمونهای شیمیایی دقیق و تکرارپذیر و استفاده از تجهیزات مدرن بخشی از فرایند کنترل اکسیداسیون هستند.
مقادیر شاخصهای شیمیایی مانند پرکسید ارزش، اسیدیته آزاد و ترکیبات آلدئیدی باید در محدوده مجاز حفظ شوند تا محصول نهایی از نظر طعم و کیفیت حسی به بهترین شکل باشد.
نقش آنتیاکسیدانها و شرایط نگهداری
یکی از مهمترین روشهای کنترل اکسیداسیون در کره و روغنهای لبنی، استفاده از مواد آنتیاکسیدانی طبیعی یا سنتزی است. ویتامین E، اسیدهای فنولیک، گلوتاتیون و سایر آنتیاکسیدانها به عنوان مهارکنندههای قوی اکسیداسیون شناخته شدهاند.
همچنین شرایط مناسب نگهداری مانند دمای پایین، جلوگیری از تماس با نور و هوا، بستهبندیهای آکنده از گازهای محافظ (N2 یا CO2) و نگهداری در محیط استریل، نقش بسزایی در کاهش روند اکسیداسیون دارند.
تکنیکهای پیشرفته آنالیز شیمیایی
امروزه استفاده از دستگاههای HPLC، GC-MS، LC-MS و ICP-OES در آزمایشگاههای تخصصی کنترل کیفیت محصولات لبنی کاربرد فراوانی دارد. این تکنیکها امکان اندازهگیری دقیق ترکیبات مختلکننده طعم و بو، اندازهگیری میزان آنتیاکسیدانها، فلزات سنگین و آلایندهها را فراهم میکنند.
همچنین روشهای نوین مولکولی مانند qPCR در کنترل میکروبیولوژیکی مرتبط با فرآیندهای اکسیداتیو نقش مکمل دارند چرا که برخی گونههای میکروبی میتوانند در فرایند اکسیداسیون موثر باشند.
تاثیر کنترل اکسیداسیون بر سلامت و ویژگیهای حسی محصول
کنترل بهینه اکسیداسیون در کره و روغنهای لبنی نه تنها به حفظ ویژگیهای حسی مانند طعم، بو و رنگ کمک میکند بلکه از جنبه سلامت نیز اهمیت بالایی دارد. حذف ترکیبات مضر ناشی از اکسیداسیون میتواند بهبود کیفیت تغذیهای محصولات را تضمین کند.
به دلیل اینکه محصولات لبنی به طور مستقیم با سلامت انسان مرتبط هستند، پا به پای استانداردهای ISIRI و Codex، آزمایشهای مرتب کنترل اکسیداسیون بایستی انجام شود تا میزان آلودگی مواد اکسیده شده در حد مجاز باقی بماند و طعم و بوی نامطلوب ایجاد نشود.
نتیجهگیری
اکسیداسیون چربیها در کره و روغنهای لبنی یکی از چالشهای اصلی در حفظ کیفیت و طعم مطلوب این محصولات است. شاخصهای شیمیایی مانند پرکسید ارزش، اسیدیته آزاد و میزان کتونها و آلدهیدها شاخصهای کلیدی برای تشخیص سطح اکسیداسیون محسوب میشوند. با بهرهگیری از روشهای استاندارد آزمایشگاهی، تکنیکهای پیشرفته آنالیز و کنترل شرایط نگهداری مناسب، میتوان از بروز طعم و بوی اکسیداتیو جلوگیری نمود.
آزمایشگاههای تخصصی کنترل کیفیت خوراک دام، طیور و لبنیات مانند آزمایشگاه پرتو بشاش با بهکارگیری سیستمهای دقیق QA/QC و فناوریهای مدرن، نقش موثری در افزایش پایداری و سلامت محصولات لبنی ایفا میکنند.
سوالات متداول
اکسیداسیون چگونه بر طعم و بوی کره اثر میگذارد؟
اکسیداسیون منجر به تولید ترکیباتی میشود که طعم و بوی نامطبوع ایجاد میکنند و کیفیت محصول را کاهش میدهند.
کدام شاخص شیمیایی بهترین معیار برای ارزیابی اکسیداسیون است؟
پرکسید ارزش به عنوان شاخص اولیه و حساسترین معیار شیمیایی برای سنجش اکسیداسیون شناخته شده است.
چگونه میتوان اکسیداسیون در محصولات لبنی را کاهش داد؟
استفاده از آنتیاکسیدانها، شرایط بهینه نگهداری و ترویج فناوریهای نوین آنالیز، روشهای موثر در کنترل اکسیداسیون هستند.
آیا آزمایشگاهها تنها به پرکسید ارزش بسنده میکنند؟
خیر، آزمایشگاههای تخصصی علاوه بر پرکسید ارزش، اسیدیته آزاد، ترکیبات کتون و آلدهید و سایر شاخصهای پراکسید شده را برای ارزیابی کامل اکسیداسیون بررسی میکنند.
چه تکنولوژیهایی در آزمایشگاه کنترل کیفیت برای تشخیص اکسیداسیون به کار میروند؟
تکنولوژیهای پیشرفته مانند HPLC، GC-MS، LC-MS، ICP-OES و qPCR در آزمایشگاهها برای تشخیص دقیق و جامع اکسیداسیون استفاده میشوند.